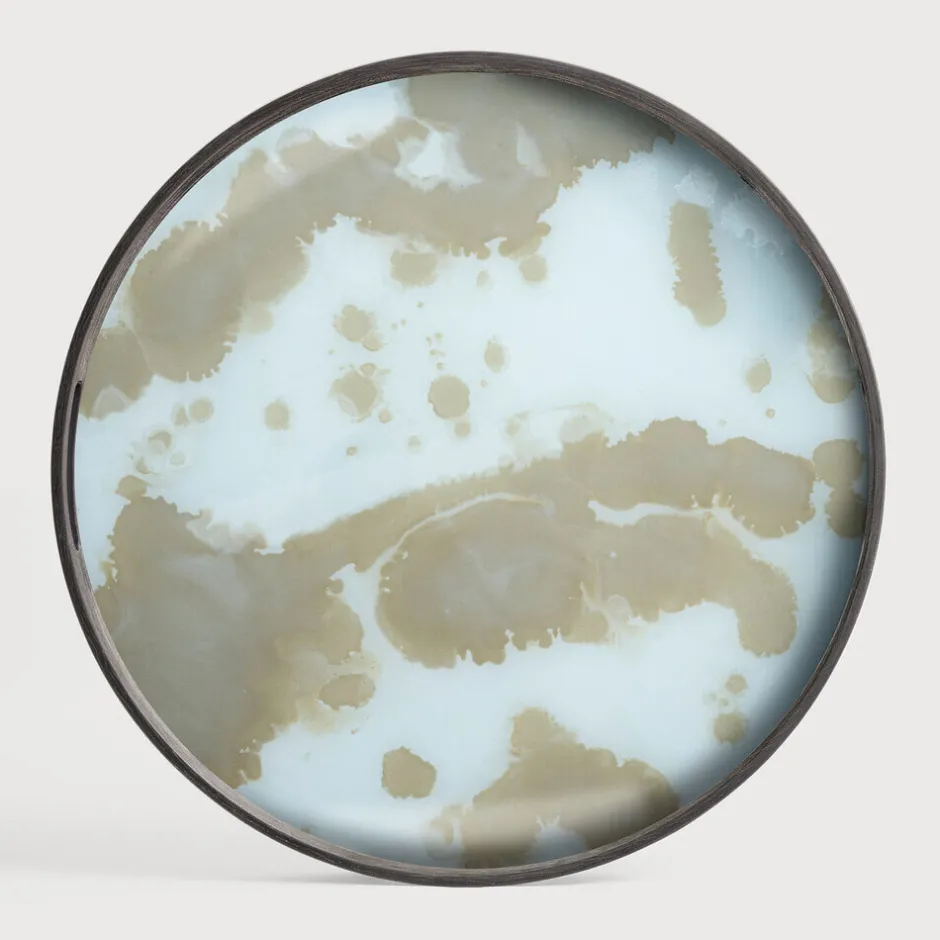

De Mystic Gold collectie van dienbladen is uitgesproken en luxueus, en zal iedere ruimte oplichten met zijn zonnige kleuren, moderne patronen en verkwikkende explosies van goud. Het contrast tussen de donkere houten randen en de lichte glazen basis versterkt de schitterende gouden tinten die overal in de collectie rijkelijk te vinden zijn.
Hot Ethnicraft Rond Dienblad Mystic Gold 48cm, kleur Gold Mist
€100.27
De Mystic Gold collectie van dienbladen is uitgesproken en luxueus, en zal iedere ruimte oplichten met zijn zonnige kleu…
| Artikelnummer: | EC-20361 |
|---|---|
| Levertijd: | Op voorraad. Levertijd: 5-10 werkdagen |
| Merk: | Ethnicraft |
| Materiaal: | Handgeschilderd glas – houten rand. |
| Montage: | Volledig afgemonteerd geleverd |
| Overige info: | Ontwerper: Dawn Sweitzer Omdat onze producten met de hand zijn gemaakt, kunnen artikelen onderling verschillen. Wij zien dit als een teken van uniciteit. |
| Breedte: | 48cm |
| Hoogte: | 4cm |
| Diepte: | 48cm |
| Maximum belastbaar gewicht: | 4,5 |
| Geschikt voor buitengebruik: | Nee |
| Onderhouds-instructie: | Onderhoudsinstructies voor dienbladen & dienbladtafels |
| Gewicht: | 2 kg |
| Aanwezig in de Concept Store? | Nee, dit artikel is niet aanwezig in onze Concept Store. Je kunt gebruik maken van onze 30 dagen bedenktermijn. |
| Color | Mist |
|---|
Wees de eerste om “Hot Ethnicraft Rond Dienblad Mystic Gold 48cm, kleur Gold Mist” te beoordelen Reactie annuleren
Gerelateerde producten
Barkruk Leer / Kunstleer
Online Ethnicraft Barkruk Osso Hout en Leder (zithoogte 67cm)
Fauteuil Stof / Textiel
Sale Ethnicraft Fauteuil Aspekt Gevernist Teakhout en stof, kleur Warm Ash Donkerbruin
Fauteuil Leer / Kunstleer
Discount Ethnicraft Modulaire Bank N701 Leder, 1-zits, kleur Old Saddle
Eetkamerstoelen
Fauteuil Leer / Kunstleer
Online Ethnicraft Fauteuil Eye Gevernist Eikenhout en leder, kleur Naturel
Eetkamerstoelen
Barkruk Hout
Fauteuil Stof / Textiel
Online Ethnicraft Fauteuil Panel Gevernist Teakhout, rotan en stof, kleur Grey Linen Donkerbruin
Fauteuil Stof / Textiel
Eetkamerstoelen
Best Ethnicraft Eetkamerstoel Bok Gevernist Eikenhout en Leder
Eetkamerstoelen
Ethnicraft Eetkamerstoel Risu Gevernist Eikenhout, kleur Naturel

Beoordelingen
Er zijn nog geen beoordelingen.